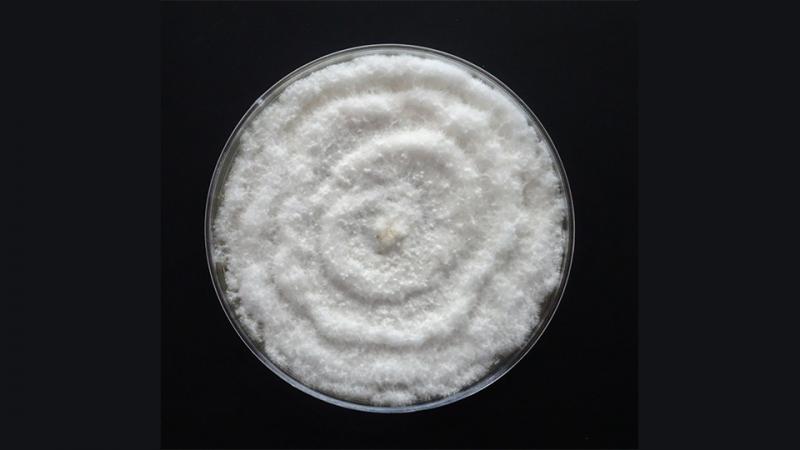
Neopestalotiopsis rosae en arándano podría tener prevalencia en diversas zonas productoras del país

(Agraria.pe) La sanidad es un aspecto fundamental para el buen desarrollo del negocio agroexportador, más cuando se trata de un producto estrella como el arándano. Por ello, las investigaciones que se hacen al respecto tienen un gran valor a modo preventivo. Y en este caso se trata del seguimiento que se hace al Neopestalotiopsis rosae, un hongo fitopatógeno que causa síntomas de decaimiento, necrosis marrón de tallos y muerte de ramas de arándano.
Según explica Jhader Álvarez Romero, agrónomo especialsta en sanidad vegetal, en algunas situaciones la sintomatología externa de esta enfermedad puede confundirse con los síntomas ocasionados por algunos hongos de la familia Botryosphaeriaceae , tales como Lasiodiplodia spp.
“Por ello, es importante realizar su identificación en laboratorio. Recientemente, en un trabajo de tesis, logramos identificar dos especies de Neopestalotiopsis en muestras provenientes de Piura. Anteriormente, el Dr. Edgar Rodríguez ya había reportado la incidencia de Neopestalotiopsis rosae en campos de arándano de Huaral y Olmos”.
El especialista concluye que estos procesos sugieren que la enfermedad tiene prevalencia en diferentes zonas productoras del país.